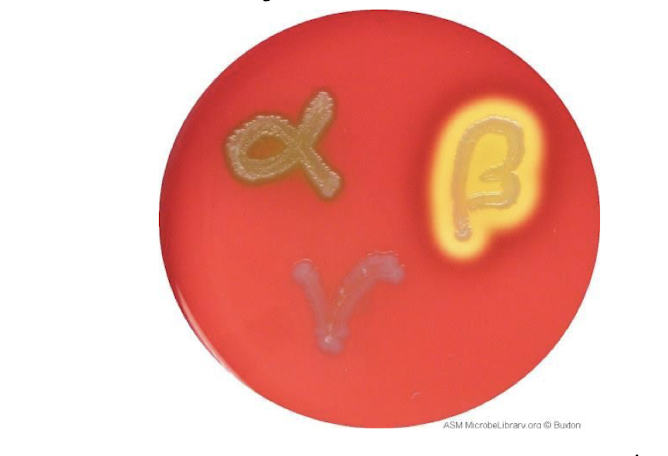

What are the general characteristics of Streptococci?
gram positive cocci
facultative anerobes
catalase-negative
colonies - smooth and mucoid
what is the grouping of streptococci into 20 lancefield groups based on?
group-specific cell wall carbohydrates
What hemolytic pattern does streptococci present?
various - aids in diagnosis
label the hemolysis on each? what agar is this?
blood agar
L - alpha
middle - gamma
R - beta
what are the envelope virulence factors of streptococci?
polysaccharide capsule
peptidoglycan and LTA
fimbrial M protein
what are the enzymes/toxin virulence factors of streptococci?
Hemolysins - streptolysins O and S
DNases
Hyaluronidase
Streptokinases/fibrinolysin
Streptococcal pyrogenic exotoxins
what does polysaccharide capsule do?
inhibit phagocytosis
impart smooth/mucoid appearance to colonies
what does peptidoglycan and LTA do?
potent pyrogens
induce cytokine secretion
LTA - adhesin
what does fimbrial M protein do?
adhesin
inhibit complement activation
antiphagocytic
associated with post-streptococcal immune response
what does Hemolysins do?
destroy RBC
responsible for beta-hemolysis on blood agar
what does DNases do?
degrade DNA, liquifies pus to facilitate spread
evade immune response
what does hyaluronidase do?
break down hyaluronic acid in ECM, facilitate spread
what does streptokinase/fibrinolysin do?
dissolve blood clots, facilitates spread
what does streptococcal pyrogenic exotoxins do?
SpeA and SpeC - super antigens - non-specific activation of T cells
what is the streptococcus causative agent of bovine mastitis?
S. agalactiae, S. dysgalactiae, or S. uberis
what are the sources of bacteria with mastitis?
bedding material, flies, milker’s hands, cross sucking, milking machine
What is the hemolysis and CAMP result of S. agalactiae?
beta-hemolytic, CAMP-positive
What is the hemolysis and CAMP result of S. dysgalactiae?
alpha-hemolytic, CAMP-negative
which streptococcus species is the contagious pathogen of mastitis? (animal to animal)
S. agalactiae
dec milk qualitty, dec milk production
which streptococcus species is the intermediate pathogen of mastitis? (environment and host)
S. dysgalactiae
What is the hemolysis and CAMP result of S. uberis?
alpha hemolytic and CAMP - negative
which streptococcus species is the environmental source of transmission of mastitis?
S. uberis
what are the somatic cells in a CMT test?
WBC
which is a positive and negative CAMP test?

A - positive
B - negative






